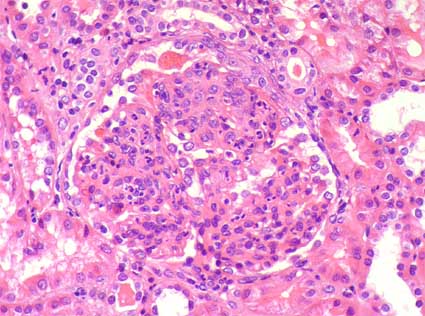

|
|
CASO
2 (Abril 2006)
Datos
clínicos
Paciente de 20 años, estudiante; un mes de evolución
de edema en cara y miembros inferiores, astenia, adinamia y disminución
leve del volumen urinario.
Consultó al hospital local donde encuentran TA:
140/100, FC 82 x min, FR: 18 x min, edema bipalpebral, sin alteraciones
cardio-pulmonares o en abdomen. Edema grado I de miembros inferiores.
Citoquímico de orina: densidad 1.015, proteínas 100 mg/dL,
y en el sedimento eritrocitos 10-15 por campo de gran aumento. Inician
manejo con IECAs y furosemida pero el paciente no mejora y disminuye más
su volumen urinario por lo cual remiten.
Al ingreso encuentran paciente edematizado, TA 160/100,
FC 90 x min, FR: 16 x min. Hidratado, sin IY. RsCsRs, no S3 ni frote,
sin alteraciones pulmonares, abdomen blando sin dolor. Extremidades: edema
grado II. Hb 12 g/dL, leucocitos: 10.000, plaquetas: 201.000/mL. Creatinina:
3,8 mg/dL, BUN: 50 mg/dL, CrCl: 24,1 ml/min, proteinuria 1.000 mg/24 horas.
Complemento normal, ANAs negativos, AELOs: negativos,
glicemia normal. Colesterol total: 210 mg/dL, trigliceridos: 100mg/dL,
HDL 50 mg/dL, LDL 103 mg/dL.
Se toma biopsia renal. Observe las imágenes.
Figura 1.
(H&E, X400)

Figura 2.
(H&E, X400)

Figura 3.
(Plata-metenamina, X400)

Figura 4.
(Inmunofluorescencia para IgG, X400)

Figura 5.
(Inmunofluorescencia para C3, X400)
La inmunofluorescencia para IgA, IgM y C1q fueron negativas.
¿Cuál es su diagnóstico?
Ver diagnóstico
y discusión
[Arriba] |
|